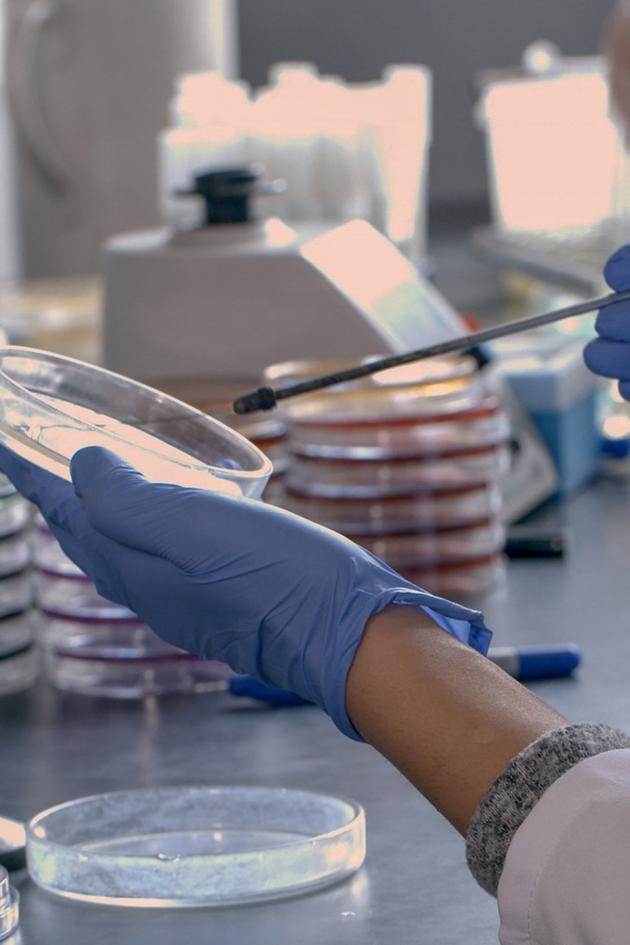
Bacteria Killers

Bacteria Killers
2019Documentary • Special • Science
Only available to new users billed through Philo. Limited time only. Philo may modify or cancel offer at any time. After first month, subscription will auto-renew at $33/month plus tax. To stop future renewals, go to your account page and cancel your subscription. Offer subject to promotion terms. See our Terms of Service for full details.
Synopsis
Viruses can become humanity's best weapon against antibiotic resistance, after an exciting history spanning hundreds of years and several continents.Genres
Documentary, Special, Science, Public affairs, HealthFrequently Asked Questions
- Yes! You can record an unlimited amount of live or upcoming content to your cloud DVR and save them for up to a year. No equipment needed!

- HBO Max:
- Sign up for Philo
- Go to your Philo account page and follow the steps to activate your HBO Max Basic with Ads plan account.
discovery+:- Sign up for Philo
- Go to your Philo account page and follow the steps to activate your discovery+ account.
- Once your account is activated, you can sign in to HBO Max and discovery+ apps with your email and password to start watching.
- An email address
- A future payment method
- A broadband internet connection
- A supported device
Web, iPhone & iPad, Android phones & tablets, Roku, Fire TV, Samsung TV, VIZIO TV, LG TV, Apple TV, Android TV, and Chromecast via Android- With your Philo Core subscription, you’ll unlock a world of entertainment. You can enjoy over 70 top-rated live channels, thousands of titles on demand, and the AMC+ library of groundbreaking originals, blockbuster movies, and classic collections. Plus, access to HBO Max Basic with Ads plan and discovery+ for just $33/month when you sign up on Philo.com.









